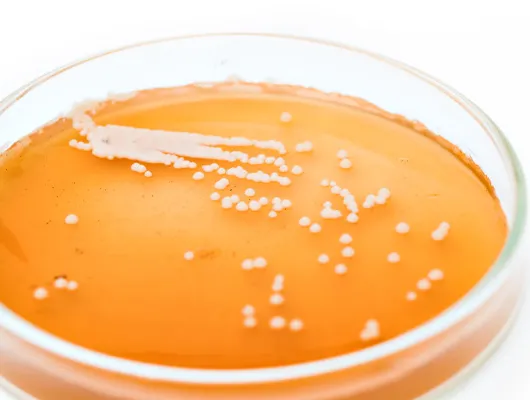
élesztő' title='Yeast Egy romantikus történet

A komló minden figyelmet kap—az összeshírnévszójátékokésdicsőség, míg az élesztő szinte minden munkát elvégez.A komló uralja a címketeret, és az olyan fajták, mint a Cascade Strata és a Citra, gyakorlatilag az otthoni nevek, köszönhetően az IPA minden kategóriája iránti látszólag csillapíthatatlan keresletnek.Még alapvetősör hanem élesztőSaccharomycessöra legtöbb ember számára elvontszinte kimondhatatlan, és senki nem beszél róla a bulikon, és nem tetovál rá sörfesztiválokon. Komló nélkül lehet sört készíteni, de élesztő nélkül nem.
A komló minden bravúrja mellett a sör ízleíróinak 79%-a származik-tólvagy élesztővel módosított. Valójában mindegyikkategóriája érzékszervi leírást érinti az élesztő.Az élesztő befolyásolja az aroma érzetét és megjelenését a szájban—homályos IPA-t csinál’s köd.
sörfőzdék albuquerque belvárosában
Az erjesztés az a folyamat, amelynek során az élesztő felveszi a cukrot, és azt CO2-vé és alkohollá metabolizálja.A sörfőzés egyik legfontosabb eleme annak biztosítása, hogy az élesztővanboldog és egészséges. Ha nem, a sör szörnyű lesz. Minőségellenőrzési osztálysfigyelemmel kíséri az élesztő állapotát, hogy a sör iható legyen. Minőségellenőrzés nélkül akár a szemétbe is dobhatja a komlót.
Az élesztő körülöttünk van. Azspórák vannakporszemcséken lebeg a levegőben és élesztő még éla bőrünkönszabad szemmel láthatatlan. Az élesztő az egyik legrégebbi háziasított szervezet a sörfőzés kezdete ótaMezopotámiában ie 5000 körül. (Viszont komlónem voltakt általában sörre használták egészen a középkorig.)
William Bostwick írja beA Brewer’s Mese: Történelem Beer szerint Mi nem’t igazán sört főzni. Az élesztő igen. A sörfőző csupán előkészíti a terepet az élesztő számára, hogy végrehajtsa az erjedés varázsát.Bostwick írjaA sörfőzés arról szól, hogy átvegye az irányítást a természet felett, megszelídítse a spórákat, és a nyersből főtt formát alakítson át. Téhes élesztőspórák lebegnek, készen arra, hogy találjanak egy édes ételt és kezdjenek dolgozni. A sör esetében a cukrok malátából származnak.
Az élesztő a hőmérsékleti idővel szabályozhatóésoxigént az általunk megadott paraméterekre erjeszteni’beállítottam.Ennek a vad varázslatos láthatatlan elemnek a művelése végül meghatározta az összes sörkategóriát, amelyet ma élvezünk. Annak ellenére, hogy az élesztő szerepét egészen Louis Pasteurig nem értették meg’s mikrobiológiai munkája a 19. században brewersmegtanulta háziasítani az élesztőt hozzáadásávalegy kis sörtaz utolsó tételből (vagy egy benne ázott fadarabot) behogyaújegy jó főzethez. Így minőségellenőrzésáltal létezettélesztő újranövekedése jó sörtételekből és rosszak kidobásaazelőtt voltak laboratóriumok polimeráz láncreakciós (P.C.R.) tesztekkel.
Az erjedés során az élesztő más ízeket is hoz létre, miközben felveszi vagy lebontja a cukrokat. Ezek a metabolitok közé tartoznak a gyümölcsös észterek, fűszeres füstös fenolok, fusel-alkoholok, vajas diacetil-kénsavak és még sok más, ami megfelelő és meghatározó a sörstílusokhoz—mégis undorító lehet, ha egy bizonyos küszöb felett vannak.Csillapításmennyi cukrot metabolizál az élesztőis fontos. Nemcsak az alkoholtartalmat határozza meg, hanem a maradék cukrok is óriási hatással vannak az érzékszervi élményrea gyengítetlen sör pedig táptalaja lehet olyan szennyeződéseknek, mint a baktériumok és a nem kívánt vadon élő élesztők, ha nem ellenőrzik.
A minőség-ellenőrző laboratóriumban a labortechnika megszámolja az élesztőt, és meghatározza, hogy mennyi kell belőle az optimális idő alatt a betakarításhoz és a szurkoláshoz, valamint figyelemmel kíséri állapotát. A PCR tesztek ellenőrzik a szennyeződést.IgenaA sörnek nincs íze, hogy készen áll-e a csomagolásra, és megfelel-e a márkaprofilnak?
A minőség-ellenőrző laboratóriumban a labortechnika megszámolja az élesztőt, és meghatározza, hogy mennyi kell belőle az optimális idő alatt a betakarításhoz és a szurkoláshoz, valamint figyelemmel kíséri állapotát. A PCR tesztek ellenőrzik a szennyeződést.IgenaA sörnek nincs íze, hogy készen áll-e a csomagolásra, és megfelel-e a márkaprofilnak?
sörök és márkák típusai
A minőség-ellenőrzés nagyon fontos. Minden sörgyárnak rendelkeznie kell minőség-ellenőrző részleggel – mondta Judy Elhamalawy, aki kidolgozta a minőség-ellenőrzési programot a Five Boroughs Brewing Co. mikrosörfőzdében, Brooklyn NY-ban.
Az alacsony dobás stresszhez vezet az élesztőben. Nehezebben szívja fel a diacetilt, ami megnöveli a tartályban töltött időt, ami összezavarja a gyártási ütemtervet – mondta Elhamalawy.Élesztőmutációhoz és versengő fertőzésekhez vezethet, mivel az alkohol nem’t kellően gyorsan előállítani.
A túlzás az élesztő mutációjához vezet‘lustább verziók’ ami csökkenti a hatékonyságot és elronthatja a gyártás ütemezését – mondtaA stresszes élesztő hidrogén-szulfidhoz vagy rothadt tojásszaghoz vezethet.
Az erjesztés után a labor biztosítja, hogy mikroszinten a sör megfeleljen az egyes márkák paramétereinek. Szénsavas tiszta és jó elhagyni a sörfőzdét. Elhamalawy szerint ha egyszer a sörök kikerülnek a világbaa legrosszabb, amit a bárok tehetnek a sörrel, hogy nem tisztítják meg a vonalukat.
füstölt de
A labor mellett szenzoros paneleket is alkalmaznak, hogy megbizonyosodjanak arról, hogy a tudomány helyes ésa minőség állandó Minőségbiztosítás.Megvizsgáljuk az egyes márkák attribútumait, például a stoutunkat, és egy tartományon belül skálázzuk – mondta Amanda Benson, a Deschutes sörfőzde Érzékelő Panel-koordinátora, Bend Oregonban.
A panelek akár 15 mintát is megkóstolhatnak, hogy az egyes márkákhoz tartozó érzékszervi paraméterek alapján keressenek hibákat a sörben. Benson szerint a házi élesztő egy angol törzs, és hajlamos a diacetil- és izoamil-acetátra, egy észterre, amely banánízt és -szagot hoz létre, ezért ellenőrizniük kell, hogy az elfogadható tartományon belül van-e.
Ha valami elromlott, megnézik a receptet, hátha van mit javítani.Sokszor csak nézünk és várunk – mondta. Például Lil’ A lédús, lédús Pale Ale squeezy-nek enyhe kénes szaga volt, ami megrázó volt, de alábbhagyott.Vártunk rá és elhalványult. Rájöttünk, hogy az erjedési folyamat része.
A sörnek van egy olyan kategóriája, ahol az élesztőt kapják a legjobban, ez pedig a Wild Ale. A vadon élő söröket kombinált vagy vegyes kultúrával fermentálják, amely a Saccharomyces mellett Brettanomyces-t és más mikrobákat is tartalmaz. A Denver Coloradoból származó Crooked Stave savanyú és vad sörökről, valamint a tudomány és a művészet ötvözetéről ismert.
De ha vad az vad? És még a minőséget is ellenőrizheti?
A vad és savanyú söröknél nem’t sok labormunkát végezni. Mérjük az ABV kalóriákat és figyeljük az erjedést – mondta Jordan Fey Crooked Stave’s sörfőzde és minőség-ellenőrzési koordinátor.Mikroteszteket futtatunk, hogy megbizonyosodjunk arról’nem kerül be semmilyen savanyú baktériumrozsdamentes tartályok, és biztosak akarnak lenni abban, hogy a savanyúság a végén legyen.
Ezekért a sörökért nem’ne aggódj a hangmagasság miatt.Az egyik szórakoztató dolog számunkra, hogy nem adunk hozzá élesztőt. Nyitott etetőben elsődlegesen erjesztjük, hozzáadva a benne lévő élesztős pogácsához.
A Crooked Stave-nél, míg atiszta éssavanyú A söröket ugyanazon a tető alatt erjesztik, így biztosítják, hogy a színkódolási rendszer ne okozzon keresztszennyeződést. Minden Brettnek más színvilága van, mint a Saccharomyces-nek, így a felszerelés nem’t keveredni.
Groler srácok seattle
Mennyire savanyú a savanyú? Egy másik íz-arány, amelyet a Crooked Stave tesztel, a savanyúság.Mifuss titrálható savasságotsavanyú sörünkön a laborban. Ez a mennyiséget teszteliltaktikaacid jelen van minden savanyúban, és lehetővé teszi számunkra, hogy számot adjunk a sör savanyúságára - mondta Fey. Szeretjük ezt a csaptelep oktatási darabjaként használni, amely tudást ad a sört készítőinek, amit átadnak a fogyasztóknak, amikor valaki bemegy és megkérdezi.‘milyen savanyúak a söreid?’vagy melyik a legkevesebb vagy legsavanyúbb.
Míg a vadon élő élesztőt a gyümölcsök héjából, a szakállból vagy a régi hordókból lehet betakarítani otthon, a kereskedelmi sörfőzők vad élesztőt és vegyes kultúrákat is vásárolhatnak élesztőbankokból, például a White Labs-tól. Utasításokkal és ajánlásokkal vannak ellátva.
Az élesztőt az idők során félreértették és mindenütt jelen voltak, még akkor is, amikor az erjesztést tisztelték.—a levegőben, amit belélegzünk, és a bőrünkön. Gondos ellenőrzéssel és manipulációval a sörfőzők és a minőség-ellenőrzési menedzserek biztosítják, hogy az élesztő elkészítsefinom, kifinomult kézműves folyadékok ahelyett, hogy az ihatatlan mellékízek undorító koktéljává robbannának a szájban. A civilizáció mindig is mély kapcsolatban állt az élesztővel és az erjesztéssel.Lehet, hogy a komlónak van néhány szójátéka, de az élesztő egy vidám fickó, édesszájú, aki mindig ott van.

Melissa Surach
Melissa Surach író, humorista és alkalmanként házi sörfőző. Cicerone Certified Beer Server, MFA-val rendelkezik írásban, és jelenlegi munkája a New York-i Beer Rep. Kúszását követheti a Twitteren @melissasurach és az Instagramon a @dirtyapartmentscab oldalon.














